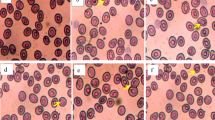

Abstract
This study aimed to evaluate to what extent diel water temperature oscillations over a short period of time (41 h) affected haematologic and plasmatic parameters of gilthead sea bream. Sea bream juveniles (160 fish; 177.2 ± 20.9 g) were divided in two homogenous groups, experimental and control. The experimental group was exposed to water at 22.3 ± 0.6 °C between 5 a.m. and 5 p.m. and to colder water from 5 p.m. to 5 a.m. (temperature variation of 8.6 ± 0.3 °C) during 41h period, whereas for the control group, water temperature was maintained constant (22.4 ± 0.7 °C) for the same period. Fish were fed three times per day (10:30 a.m., 2 p.m., 4 p.m.). Blood was collected from fish caudal veins (n = 6) at different time points (10 a.m., 1 p.m., 5 p.m., 6:30 p.m., 8 p.m. and 10 a.m. of the following day) from each group, for haematologic (haematocrit and haemoglobin) and plasmatic (glucose, cortisol, triglycerides and total protein) determinations. All parameters studied tended to vary throughout the study period, both for experimental and control groups. Significant differences were observed between the two groups for all the studied parameters at different sampling points. These differences were observed near the influence of the cold-water period or during the cooling-water period. Results suggested that colder water temperature cycles depressed fish metabolic activity and affected the levels of the analysed blood-circulating metabolites. Overall, results suggested that stress response was similar for experimental and control groups and that gilthead sea bream were able to cope with diel water temperature variations.
Similar content being viewed by others
Avoid common mistakes on your manuscript.
Introduction
Temperature is one of the most important factors affecting the growth and development of ectothermic organisms, since it influences body functions like food consumption, feed conversion, metabolism, growth rate and overall fish health (Johnston and Dunn 1987). For gilthead sea bream, one of the most important species of marine aquaculture in the Mediterranean Sea (Basurco et al. 2011), the optimal interval rearing temperatures is between 18 and 26 °C (Jobling and Peruzzi 2010). In earthen ponds and sea cages, these limits can be even wider (28 °C in summer and 11 °C in winter) (Cardia and Lovatelli 2007), reflecting the tolerance and robustness of this fish species for production. Although gilthead sea bream is considered a relatively robust species, it has been shown to be particularly sensitive to cold. The latter feature leads to the occasional occurrence of a disease called the winter syndrome (Ibarz et al. 2010), suggesting that this species is sensitive to temperature changes. Therefore, day/night water temperature changes might act as a stressor, causing fish to undergo a series of biochemical and physiological changes to cope with the new rearing conditions.
Like other vertebrates, fish exhibit a generalized stress response that is characterized by an increase in stress hormones, such as cortisol, and the consequent changes at the physiological level, including blood characteristics (Barton et al. 2002; Peres et al. 2013; Wells and Pankhurst 1999). In this sense, changes in the concentration of haematocrit, haemoglobin, total protein, glucose, triglycerides and cortisol were used as indicators of physiological response in fish. An increase in plasma cortisol levels is generally followed by an elevation in plasma glucose levels to supply the greater energy demand caused by the stress-induced increased mechanisms and to meet the energy required to sustain increased physical activity (Martínez-Porchas et al. 2009; Mommsen et al. 1999; Wells and Pankhurst 1999). For the same reason, fish also mobilizes plasma triglycerides and proteins (Kyprianou et al. 2010; Sala-Rabanal et al. 2003). Additionally, haematological parameters including haematocrit and haemoglobin are good indicators to assess how exposure to stress can be minimized to better manage fish health (Chen et al. 2004; Eslamloo et al. 2014).
The aim of this study was to evaluate the early physiological response of juvenile gilthead sea bream (Sparus aurata) caused by temperature oscillations during a short period of time, by analysing some blood and plasmatic parameters in order to understand the vulnerability of this species to day/night temperature changes.
Materials and methods
Fish rearing conditions
Fish juveniles used in this study (11 months old) were obtained from a single spawn of a gilthead sea bream broodstock maintained at the Aquaculture Research Station of IPMA (EPPO, Olhão, Portugal). Fish were reared under standard protocols for sea bream (Pousão-Ferreira et al. 2005) until used for this study. One month before the study, 160 fish (177.2 ± 20.9 g) were transferred for 1500L circular fibreglass, supplied with flow-through gravel-filtered, aerated seawater (salinity 34 ppt; dissolved oxygen range 65–85%) and temperature maintained at 22.4 ± 0.7 °C. The photoperiod was 14h light and 10h dark (14L :10D), with lights on at 9 a.m. Fish were fed three times a day (10:30 a.m., 2 p.m. and 4 p.m.), by hand to apparent satiety, where the interval between 5 p.m. and 10:30 a.m. of the subsequent day was referred to as ‘night-time nonfeeding period’.
All fish manipulations were directed and carried out by trained scientists (following category C FELASA recommendations) and were conducted according to the European guidelines on protection of animal used for scientific purposes (Directive 2010/63/UE of European Parliament and of the European Union Council).
Experimental conditions — day/night temperature oscillations
In order to evaluate to what extent daily water temperature oscillations affected fish haematologic and plasmatic parameters, fish were divided in two homogenous groups, experimental and control, each with 80 fish. For the experimental group, fish were exposed to daily water temperature manipulations (22 °C during daytime and 15 °C during night-time), whereas for the control group, fish were maintained with constant water temperature during the whole day (22 °C).
Water temperature in the experimental group, maintained at 22.3 ± 0.6 °C until 5 p.m., was programmed to decrease after this hour. At this moment, the running warm water was replaced by a cold one. Water temperature took around 5 h to reach 14.9 ± 0.8 °C, when the maximum difference between temperatures was attained (8.6 ± 0.3 °C), and was maintained at this value for 7 h. At 5 a.m., water temperature started to increase, taking approximately 5 h to reach again the temperature of the warm water (around 22 °C). The temperature variation for both groups, experimental and control, is shown in Fig. 1. The experimental period lasted for 41 h, where the experimental group was exposed to two periods of low water temperatures during the night, whereas the control group was maintained at warm water temperatures (22.4 ± 0.7 °C) the whole experimental period. No behaviour alterations or mortality occurred during this period for fish from both groups.
Temperature variation during the experimental period (41 h) of the water tanks containing gilthead sea bream juveniles from control (solid line) and experimental (dashed line) groups, comprising the beginning of water temperature manipulation (5 pm) and the 24h sampling period (10 a.m. to 10 a.m. of the subsequent day). Solid arrows represent the sampling time (10 a.m., 1 a.m., 5 p.m., 6:30 p.m., 8 pm) and the black stars the feeding time (10:30 a.m., 2 p.m., 4 p.m.). The shaded area represents the cold-water period (5 p.m. to 5 a.m.). The temperature variation periods and their duration are indicated. White and black bars above each graph represent light and darkness, respectively
Water temperature oscillations were managed through a heat-pumping system, composed by one heat pump and two independent electropumps, which was used to insure the warm water running into the tanks. While one electropump worked on a continuous basis to pump the warm water into the tanks, the second one only worked during daytime, when a larger amount of warm water was required. A daily analogic programmer (set from 5 a.m. to 5 p.m.) controlled the operation of this second pump. A chiller system was used to cool down the water temperature (Carrier), which was distributed to the tank of the experimental group, only from 5 p.m. to 5 a.m. (set by an electronic programmer, Rain Bird Image6). During this time period, warm water temperature stopped running into the experimental group tank. The water temperature was monitored using the SINERGIA® system (Fernando Ribeiro Lda., Portugal).
Blood sampling
Six fish from each tank were sampled at different time points (10 a.m., 1 p.m., 5 p.m., 6:30 p.m., 8 p.m. and 10 a.m. of the following day) for blood collection. Sampled fish were transferred to a different tank to ensure that the same individuals were not repeatedly sampled. Fish were not anaesthetized due to the possible effects of anaesthetics in plasma glucose and cortisol levels (Ortuño et al. 2002). The time elapsed from capture to blood withdrawal was less than 5 min. Approximately 1 ml of blood was collected with heparinized (5 mg/ml) syringes from the caudal vein for haematological and plasmatic parameter analyses. Blood samples were immediately processed after collection to avoid clotting and haemolysis. After the collection of blood sample, fish mass (g) was measured and fish were released.
Haematological analysis
Prior to plasma extraction, a sub-sample of blood from each fish was used for haematocrit and haemoglobin analyses. Blood was placed into a capillary tube for haematocrit determination (Ribeiro et al. 2015). Haemoglobin determination was carried out by using a commercial kit (1001230, Spinreact), based on the Drabkin colourimetric principle (Drabkin and Austin 1935). All the samples were examined in duplicate and analysed on a microplate reader at 540 nm (Multiskan GO, Thermo Scientific).
Plasmatic parameters
The remaining blood, collected from each individual fish, was centrifuged at 2500×g for 10 min to obtain plasma, which was stored at − 80 °C until analysis, as described in Ribeiro et al. (2015). Cortisol was determined using a cortisol ELISA kit test (RE52611, IBL International) already validated for sea bream samples (López-Olmeda et al. 2009). Plasma glucose was determined using a clinical diagnostic kit (998225, QCA), based on the sequential reactions of glucose oxidase (GOD) and peroxidase (POD), and was read at 505 nm. Total protein was determined in plasma using a clinical kit (997180, QCA) based on the biuret method (Gornall et al. 1949) and was read at 540 nm. Plasma total protein was measured using bovine albumin as reference. Plasma triglyceride concentration was determined by using a clinical diagnostic kit (992310, QCA), based on sequential enzymatic reactions, and was subsequently read at 505 nm. All the plasmatic parameters were determined in duplicate and analysed through colourimetric reaction on a microplate reader (Multiskan GO, Thermo Scientific).
Statistics and graphics
Values were reported as the mean ± SEM. Means for each parameter were compared between groups at each sampling point, considering each single fish as a replicate (n = 6). Statistical analyses were performed using IBM-SPSS Statistics v20 software. The values obtained at each sampling point for cortisol, triglycerides, glucose, haematocrit, haemoglobin and total protein were compared among groups using one-way ANOVA, after confirming data normality and homoscedasticity. Results were considered significant at the 95% confidence level (p < 0.05). Graphics were prepared using GraphPad Prism 5 software.
Results
Haematocrit and haemoglobin
At 10 a.m., fish from the experimental group exhibited a significantly (p = 0.001) lower haematocrit concentration level than the control group. From 1 p.m. to 5 p.m., haematocrit levels remained very similar for both groups, with no significant differences. During the cooling period, the fish from the experimental group exhibited a decrease in their haematocrit levels (6:30 p.m., p = 0.002 and 8 p.m., p = 0.000), when compared to the values from the control group. Afterwards, haematocrit values of the experimental group increased again, reaching in the morning similar levels as those observed in the morning before (Fig. 2a).
Haematocrit (Hct) (a) and haemoglobin (Hgb) (b) values of gilthead sea bream from control (solid line) and experimental (dashed line) groups. Values represent the mean ± SEM (n = 6) in each sampling time point. Solid arrows represent the sampling time (10 a.m., 1 a.m., 5 p.m., 6:30 p.m., 8 p.m.) and the black stars the feeding time (10:30 a.m., 2 p.m., 4 p.m.). The shaded area represents the cold-water period (5 p.m. to 5 a.m.). White and black bars above each graph represent light and darkness, respectively. Different letters indicate statistically significant differences between time points (one-way ANOVA, p < 0.05)
From 10 a.m. till the beginning of the cooling period (5 p.m.), the haemoglobin variation pattern observed for both groups was very similar although with different magnitudes. This difference was the largest in the beginning of the sampling period (10 a.m., p = 0.005; 1 p.m., p = 0.021 and 5 p.m., p = 0.021) where the haemoglobin values of the fish from the experimental group were about twofold lower than the values registered for the fish from the control group. During the night-time nonfeeding period, while the haemoglobin levels of the fish from the experimental group varied slightly, the haemoglobin levels of the fish from the control group dramatically decreased and remained low until morning (Fig. 2b).
Glucose and cortisol
Cortisol levels displayed similar variability tendency for both treatments and a large variability among individuals. In the first sampling point, the group of fish from the experimental group showed significantly lower levels of cortisol when compared to fish from the control group (10 a.m., p = 0.000). The cortisol levels of the experimental group rose during the day, reaching a peak around 5 p.m. Thereafter, cortisol concentration decreased by the end of the day (8 p.m.) to the same levels as those observed at 10 a.m. of the same day of sampling (p = 0.005). Subsequently, cortisol levels exhibited a new increase, reaching a new peak in the subsequent morning (Fig. 3a).
Cortisol (a) and glucose (b) concentrations of gilthead sea bream from control (solid line) and experimental (dashed line) groups. Vertical bars represent the standard error of the mean (n = 6) in each sampling time point. Solid arrows represent the sampling time (10 a.m., 1 a.m., 5 p.m., 6:30 p.m., 8 p.m.) and the black stars the feeding time (10:30 a.m., 2 p.m., 4 p.m.). The shaded area represents the cold-water period (5 p.m. to 5 a.m.). White and black bars above each graph represent light and darkness, respectively. Different letters indicate statistically significant differences between time points (one-way ANOVA, p < 0.05)
In the beginning of the sampling period, fish from the experimental group exhibited significantly higher glucose concentration values when compared to the fish from the control group (10 a.m., p = 0.014) (Fig. 3b). Thereafter, glucose levels exhibited by the fish of the experimental group were very constant throughout the experimental period. During daytime, fish from the control group exhibited an abrupt increase of glucose levels followed by a decrease during night-time. In the morning of the next day, glucose concentration was again higher for the fish from the experimental group (10 a.m., p = 0.000). The lowest glucose concentration values were detected in the morning (10 a.m.) for both groups.
Total protein and triglycerides
The variation pattern of plasma triglyceride and total protein values was homogenous for both groups until incoming in the cooling period (5 p.m. to 10 p.m.) (Fig. 4a, b). At 8 p.m., fish from the experimental group demonstrated a small increase in the triglyceride values relative to the other group (p = 0.001) (Fig. 4a). This increase was observed during the night-time nonfeeding period. Also, a few hours earlier in the night-time nonfeeding period (6.30 p.m.), the fish from the experimental group displayed a decrease of total plasma proteins (p = 0.032) in relation to the fish from the control group (Fig. 4b).
Triglyceride (a) and total protein (b) concentrations of gilthead sea bream from control (solid line) and experimental (dashed line) groups. Vertical bars represent the standard error of the mean (n = 6) in each sampling time point. Solid arrows represent the sampling time (10 a.m., 1 a.m., 5 p.m., 6:30 p.m., 8 p.m.) and the black stars the feeding time (10:30 a.m., 2 p.m., 4 p.m.). The shaded area represents the cold-water period (5 p.m. to 5 a.m.). White and black bars above each graph represent light and darkness, respectively. Different letters indicate statistically significant differences between time points (one-way ANOVA, p < 0.05)
Discussion
Haematological and plasmatic parameters provide an insight to the physiological status of the animals. The monitoring of these parameters is a useful practice to assess the effects of the husbandry conditions applied in fish farms. The present study was conducted to analyse the short-term variation pattern of several blood and plasmatic parameters of juvenile gilthead sea bream (S. aurata) exposed to day/night temperature oscillations in order to evaluate physiological stress responses caused by diurnal fluctuations in rearing temperatures.
The experimental group exhibited significantly lower haemoglobin and haematocrit concentrations than the control group, in the morning (10 a.m.) and during the cooling period (5 p.m., 6.30 p.m. and 8 p.m.). Although it was described that an acute stress can cause the enhancement of haematocrit and haemoglobin levels (Olsen et al. 2008; Suski et al. 2007), the low levels found for these haematological parameters in response to day/night temperature variations can be explained by the depression of the metabolic rate of gilthead sea bream described in response to cold (Ibarz et al. 2010, Adeyemo et al. 2003). Additionally, the solubility of oxygen in colder water is higher compared to warmer water; consequently, fewer red blood cells might be required to carry oxygen around the body of the fish in colder temperature, as the oxygen is more readily available and the metabolic rate might be lower. Taken together, these results support the notion that fish have the strategy of adjusting blood capacity to carry oxygen under a different energy demand condition (Eslamloo et al. 2014).
Cortisol levels displayed large variability among individuals, regardless of treatment, reflecting the different physiological responses of each fish. Despite this variability, cortisol levels tended to be higher during the day to become lower during the evening. This tendency was already described for gilthead sea bream, where a relationship between cortisol and feeding cycles was observed (Montoya et al. 2010). Cortisol levels are increased during the feeding phase of the fish in order to stimulate activity to mealtime. During the night, the drop in cortisol levels could be a result of a decreased need to maintain activity for feeding (Cousineau et al. 2014; Montoya et al. 2010; Vera et al. 2014). Globally, our observations suggest that cortisol levels could be associated with feeding but likely are unrelated to water temperature.
The stress response in fish is accompanied by an increase in cortisol levels, which in turn is generally followed by an elevation in plasma glucose levels (Mommsen et al. 1999). Curiously, while the fish from the experimental group showed lower cortisol levels when compared to the fish from the control group, plasma glucose followed the opposite tendency, where higher levels of this metabolite were found in fish from the experimental group when compared to the control group. These observations seemed to reflect a lower metabolism in fish maintained at colder temperatures and consequently lower glucose utilisation for basic functions. Moreover, lower glucose values were also observed in fasted fish (18 h after the last meal), and the observed differences between groups might be related to some delay on the digestive activity of the fish from the experimental group and to the different energetic requirements of both groups, as described for several fish species (Cousineau et al. 2014; Montoya et al. 2010; Pavlidis et al. 1997; Polakof et al. 2007). During the feeding phase, differences on glucose levels between groups were not so evident, since fish from both groups could easily obtain glucose from food and since water temperature was similar (around 22 °C), fish were expected to have similar energetic requirements.
During the night-time nonfeeding period, the maintenance of glucose levels for the fish from the experimental group may be directly related to the reduction of the rate of glucose utilisation (Sangiao-Alvarellos et al. 2005). All together, our results support the notion that plasma glucose levels are strongly influenced by feeding and fish metabolism.
The variation pattern of triglycerides was homogenous for both groups until the middle of the cooling period (8 p.m.), the time when a significantly small increase was observed for the fish from the experimental group relative to the other group. Triglycerides are broken down into fatty acids and glycerol, after which both can serve as substrates for energy producing and metabolic pathways. Taking this notion into consideration, perhaps, the observed differences in triglyceride concentration among groups were related to the delayed digestive activity and to the distinct energy demand condition of fish due to the different temperature conditions. The differences observed for triglyceride levels were identified in the night-time nonfeeding period. Fish maintained in control group conditions had their metabolism enhanced when compared to the other group, because warmer temperature increases the metabolic activity of aquatic organisms (Adeyemo et al. 2003). When this group of fish stopped eating, they needed to keep getting enough fuel to supply their energy demands, the reason why triglyceride resources were used and its level decreased in plasma. On the other hand, fish from the experimental group exhibited an increase in plasma triglycerides when water temperature decreased, a situation already described by some authors for gilthead sea bream exposed to the cold (Ibarz et al. 2007; Kyprianou et al. 2010). In this scenario, triglycerides were not removed from blood circulation because of the lower energy demand associated to a lower metabolism exhibited by this group of fish. Interestingly, for both groups, plasma total protein levels displayed the least variation among all parameters examined during the experimentation period. This observation demonstrates that plasma total protein levels are more stable than glucose and triglyceride levels. Still, the small disturbance of protein metabolism observed in the experimental group probably was caused by the drop in temperature at the beginning of the cooling period (Sala-Rabanal et al. 2003). Altogether, our results indicate that during the night-time nonfeeding periods, fish from the control group exhibited higher metabolism and may need plasma triglycerides and glucose instead of protein to fulfil their energetic requirements.
It should be noted that although fish from both treatments in the beginning of the sampling period (10 a.m.) are at similar water temperature, they come from different night-time conditions, which can explain the initial differences of the analysed haematological and plasmatic parameters.
The photoperiod also affects fish blood parameters (Cerdá-Reverter et al. 1998; Cousineau et al. 2014; Montoya et al. 2010), but in our experimental conditions, this effect was not observed because samples were only collected over the light period.
Globally, our preliminary results suggested that gilthead sea bream exposed to diel water temperature variation fluctuations exhibited similar stress response than fish maintained at constant temperature regime and were able to cope with these temperature changes, mainly evidenced by the response of fish exposed to the second cold-water cycle, where values of the analysed parameters tended to approach the values exhibited by the fish from the control group. In addition, these results also suggested that colder water temperature cycles depressed gilthead sea bream metabolic activity. After a short night-time nonfeeding period, gilthead sea bream kept under these rearing conditions required less amount of energy, which was mainly evidenced by the slight variation in plasmatic triglyceride and glucose levels. This work contributes to our present knowledge about gilthead sea bream physiology response to day/night water temperature variations. Since this preliminary study indicated that day/night temperature oscillations changed gilthead sea bream metabolism, it could be interesting to study the impact of this rearing condition on gilthead sea bream growth after a longer experimental period.
References
Adeyemo OK, Agbede SA, Olaniyan AO, Shoaga OA (2003) The haematological response of Clarias gariepinus to changes in acclimation temperature. Afr J Biomed Res 6:105–108. https://doi.org/10.4314/ajbr.v6i2.54033
Barton BA, Morgan JD, Vijayan MM (2002) Physiological and condition-related indicators of environmental stress in fish, Chapter 4. In: Adams SM (ed) Biological indicators of aquatic ecosystem stress. American Fisheries Society, Bethesda, pp 111–148
Basurco B, Lovatelli A, García B (2011) Current status of sparidae aquaculture, Chapter 1. In: Sparidae: biology and aquaculture of gilthead sea bream and other species. Wiley-Blackwell, pp 1–50. https://doi.org/10.1002/9781444392210.ch1
Cardia F, Lovatelli A (2007) A review of cage aquaculture: Mediterranean Sea, Chapter 498. In: Halwart M (ed) Cage aquaculture—regional reviews and global overview. FAO Fisheries Technical Paper, Rome, pp 157–187
Cerdá-Reverter JM, Zanuy S, Carrillo M, Madrid JA (1998) Time-course studies on plasma glucose, insulin and cortisol in sea bass (Dicentrarchus labrax) held under different photoperiodic regimes. Physiol Behav 64:245–250. https://doi.org/10.1016/S0031-9384(98)00048-1
Chen C-Y, Wooster GA, Bowser PR (2004) Comparative blood chemistry and histopathology of tilapia infected with Vibrio vulnificus or Streptococcus iniae or exposed to carbon tetrachloride, gentamicin, or copper sulphate. Aquaculture 239:421–443. https://doi.org/10.1016/j.aquaculture.2004.05.033
Cousineau A, Midwood JD, Stamplecoskie K, King G, Suski CD, Cooke SJ (2014) Diel patterns of baseline glucocorticoids and stress responsiveness in a teleost fish (bluegill, Lepomis macrochirus). Can J Zool 92:417–421. https://doi.org/10.1139/cjz-2014-0054
Drabkin DL, Austin JH (1935) Spectrophotometric studies: II. Preparations from washed blood cells: nitric oxide haemoglobin and sulfhemoglobin. J Biol Chem 112:51–65
Eslamloo K, Akhavan SR, Fallah FJ, Henry MA (2014) Variations of physiological and innate immunological responses in goldfish (Carassius auratus) subjected to recurrent acute stress. Fish Shellfish Immunol 37:147–153. https://doi.org/10.1016/j.fsi.2014.01.014
Gornall AG, Bardawill CJ, David MM (1949) Determination of serum proteins by means of the biuret reaction. J Biol Chem 177:751–766
Ibarz A, Blasco J, Sala-Rabanal M, Gallardo Á, Redondo A, Fernández-Borràs J (2007) Metabolic rate and tissue reserves in githead sea bream (Sparus aurata) under thermal fluctuations and fasting and their capacity for recovery. Can J Fish Aquat Sci 64:1034–1042. https://doi.org/10.1139/f07-079
Ibarz A, Padrós F, Gallardo MÁ, Fernández-Borràs J, Blasco J, Tort L (2010) Low-temperature challenges to gilthead sea bream culture: review of cold-induced alterations and “winter syndrome”. Rev Fish Biol Fish 20:539–556. https://doi.org/10.1007/s11160-010-9159-5
Jobling M, Peruzzi S (2010) Seabreams and porgies (family: Sparidae), Chapter 16. In: Le François N, Jobling M, Carter C, Blier P (eds) Finfish aquaculture diversification. CABI, CAB International, Oxfordshire, pp 361–373. https://doi.org/10.1079/9781845934941.0361
Johnston IA, Dunn J (1987) Temperature acclimation and metabolism in ectotherms with particular reference to teleost fish. Symp Soc Exp Biol 41:67–93
Kyprianou T-D, Pörtner HO, Anestis A, Kostoglou B, Feidantsis K, Michaelidis B (2010) Metabolic and molecular stress responses of gilthead sea bream Sparus aurata during exposure to low ambient temperature: an analysis of mechanisms underlying the winter syndrome. J Comp Physiol B 180:1005–1018. https://doi.org/10.1007/s00360-010-0481-y
López-Olmeda JF, Montoya A, Oliveira C, Sánchez-Vázquez J (2009) Synchronization to light and restricted-feeding schedules of behavioral and humoral daily rhythms in gilthead sea bream (Sparus aurata). Chronobiol Int 26:1389–1408. https://doi.org/10.3109/07420520903421922
Martínez-Porchas M, Martínez-Córdova LR, Ramos-Enriquez R (2009) Cortisol and glucose: reliable indicators of fish stress? Panam J Aquat Sci 4:158–178
Mommsen TP, Vijayan MM, Moon TW (1999) Cortisol in teleosts: dynamics, mechanisms of action, and metabolic regulation. Rev Fish Biol Fish 9:211–268. https://doi.org/10.1023/A:1008924418720
Montoya A, López-Olmeda JF, Garayzar ABS, Sánchez-Vázquez FJ (2010) Synchronization of daily rhythms of locomotor activity and plasma glucose, cortisol and thyroid hormones to feeding in gilthead seabream (Sparus aurata) under a light-dark cycle. Physiol Behav 101:101–107. https://doi.org/10.1016/j.physbeh.2010.04.019
Olsen RE, Sundell K, Ringø E, Myklebust R, Hemre G-I, Hansen T, Karlsen Ø (2008) The acute stress response in fed and food deprived Atlantic cod, Gadus morhua L. Aquaculture 280:232–241. https://doi.org/10.1016/j.aquaculture.2008.05.006
Ortuño J, Esteban MA, Meseguer J (2002) Lack of effect of combining different stressors on innate immune responses of seabream (Sparus aurata L.) Vet Immunol Immunopathol 84:17–27. https://doi.org/10.1016/S0165-2427(01)00387-7
Pavlidis M, Berry M, Divanach P, Kentouri M (1997) Diel pattern of haematocrit, serum metabolites, osmotic pressure, electrolytes and thyroid hormones in sea bass and sea bream. Aquac Int 5:237–247. https://doi.org/10.1023/A:1018391418801
Peres H, Santos S, Oliva-teles A (2013) Selected plasma biochemistry parameters in gilthead seabream (Sparus aurata) juveniles. J Appl Ichthyol 29:630–636. https://doi.org/10.1111/j.1439-0426.2012.02049.x
Polakof S, Ceinos RM, Fernández-Durán B, Míguez JM, Soengas JL (2007) Daily changes in parameters of energy metabolism in brain of rainbow trout: dependence on feeding. Comp Biochem Physiol A 146:265–273. https://doi.org/10.1016/j.cbpa.2006.10.026
Pousão-Ferreira P, Gonçalves CC, Dores E (2005) Larval rearing of four Sparidae species. Book of short comunications. European Aquaculture Society. Special Publication, n°36. pp 412–415. Proceedings of Larvi 2005. 4th Fish and Shellfish Larviculture Symposium. Gent, Belgium, 5–8 Setembro 2005
Ribeiro L, Moura J, Santos M, Colen R, Rodrigues V, Bandarra N, Soares F, Ramalho P, Barata M, Moura P, Pousão-Ferreira P, Dias J (2015) Effect of vegetable based diets on growth, intestinal morpholy, activity of intestinal enzymes and haematological stress indicators in meagre (Argyrosomus regius). Aquaculture 447:116–128. https://doi.org/10.1016/j.aquaculture.2014.12.017
Sala-Rabanal M, Sánchez J, Ibarz A, Fernández-Borràs J, Blasco J, Gallardo MA (2003) Effects of low temperatures and fasting on hematology and plasma composition of gilthead seabream (Sparus aurata). Fish Physiol Biochem 29:105–115. https://doi.org/10.1023/B:FISH.0000035904.16686.b6
Sangiao-Alvarellos S, Guzmán JM, Laíz-Carríon R, Míguez JM, Martín Del Río MP, Mancera JM, Soengas JL (2005) Interactive effects of high stocking density and food deprivation on carbohydrate metabolism in several tissues of gilthead sea bream Sparus auratus. J Exp Zool 303A:761–775. https://doi.org/10.1002/jez.a.203
Suski CD, Cooke SJ, Danylchuk AJ, O’Connor CM, Gravel M-A, Redpath T, Hanson KC, Gingerich AJ, Murchie KJ, Danylchuk SE, Koppelman JB, Goldberg TL (2007) Physiological disturbance and recovery dynamics of bonefish (Albula vulpes), a tropical marine fish, in response to variable exercise and exposure to air. Comp Biochem Physiol A 148:664–673. https://doi.org/10.1016/j.cbpa.2007.08.018
Vera LM, Montoya A, Pujante IM, Pérez-Sánchez J, Calduch-Giner JA, Mancera JM, Moliner J, Sánchez-Vázquez FJ (2014) Acute stress response in gilthead sea bream (Sparus aurata L.) is time-of-day dependent: physiological and oxidative stress indicators. Chronobiol Int 31:1051–1061. https://doi.org/10.3109/07420528.2014.945646
Wells RMG, Pankhurst NW (1999) Evaluation of simple instruments for the measurement of blood glucose and lactate, and plasma protein as stress indicators in fish. J World Aquacult Soc 30:276–284. https://doi.org/10.1111/j.1749-7345.1999.tb00876.x
Funding
This work was supported by AQUAENERG (PROMAR 31-03-05-FEP-0076) and DIVERSIAQUA (Mar2020 16-02-01-FMP-0066). ACM was supported by a post-doctoral grant from FCT (SFRH/BPD/117504/2016).
Author information
Authors and Affiliations
Corresponding author
Ethics declarations
All fish manipulations were directed and carried out by trained scientists (following category C FELASA recommendations) and were conducted according to the European guidelines on protection of animal used for scientific purposes (Directive 2010/63/UE of European Parliament and of the European Union Council).
Conflict of interest
The authors declare that they have no conflict of interest.
Rights and permissions
About this article
Cite this article
Matias, A.C., Ribeiro, L., Araujo, R.L. et al. Preliminary studies on haematological and plasmatic parameters in gilthead sea bream (Sparus aurata) held under day/night temperature variations. Fish Physiol Biochem 44, 273–282 (2018). https://doi.org/10.1007/s10695-017-0432-6
Received:
Accepted:
Published:
Issue Date:
DOI: https://doi.org/10.1007/s10695-017-0432-6